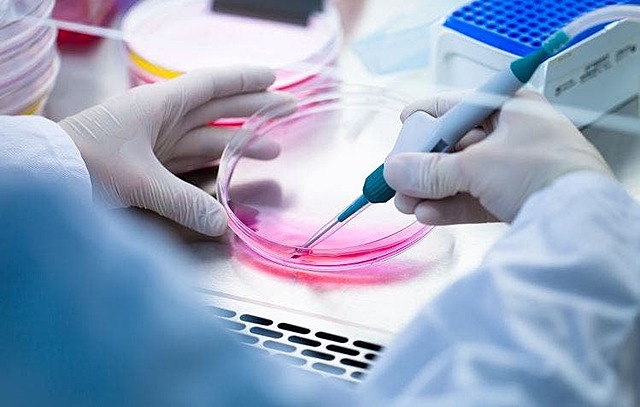
Tejidos humanos creados por la biotecnologia

-
Chain Weizmann creo un biorreactor para la producción de acetona. Durante esta fehca se libraba la primera guerra mundial, en la cual fue muy solicitado la acetona, por lo que a esta fecha se le concidera el origen de la biotecnologia
-
En 1930, utilizaron por primera vez biorreactores para la producción de levadura. El fermentador consistía en un gran tanque cilíndrico con aire introducido en la base a través de una red de tuberías perforadas.
-
De Beeze and Liebmann utilizaron por primera vez un biorreactor de esta capacidad para la producción comercial de levaduras
-
Uso de Streptomyces para la creacion de N-bromosuccinimida
-
Se empezaron a comercializar los primeros biorreactores junto con contadores de colonias y autoclaves
-
Pequeño modelo denominado biorreactor de mesa diseñado para el cultivo de células animales
-
Podían controlar hasta cuatro biorreactores, además permitía controlar al usuario ver y cambiar el parámetro del proceso
-
Con el objetivo de construir un biorreactor capaz de albergar la colonización y el crecimiento de células para formar tejidos impresos en 3D
A list shows items. A timeline shows sequence.
Use Timetoast to make dates, milestones, and turning points easier to understand in a clear visual format. Timetoast is a timeline maker for work, school, research, and stories.